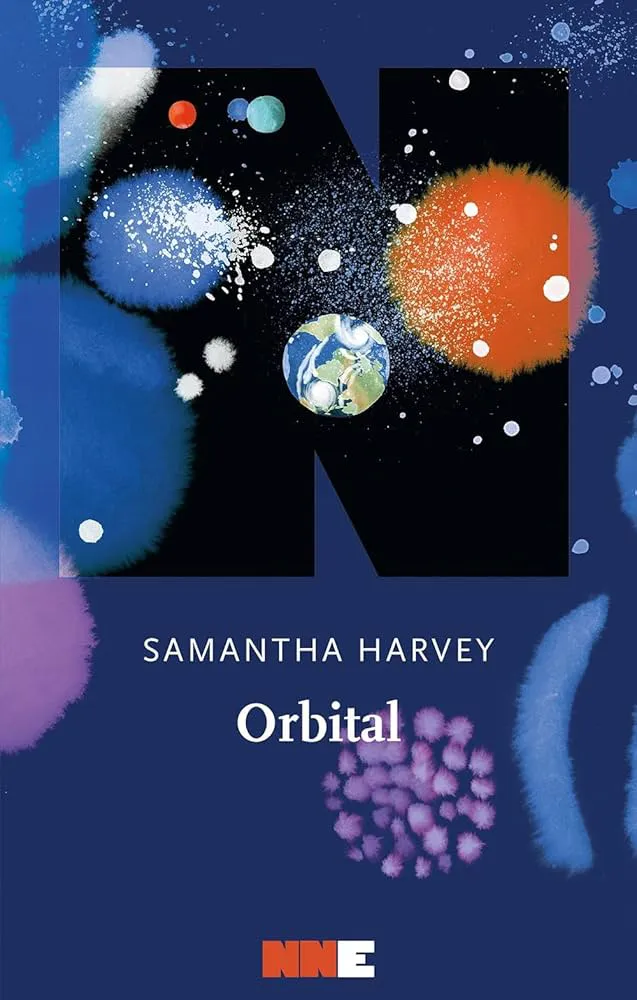
Orbital

Letture 2025

Montaigne
Stephen Zweig

A spasso con il cane Luna
Giorgio Vallortigara

Una foto è una foto è una foto
Silvia Camporesi

Sovrumano
Nello Cristianini

Uomini e topi
John Steinbeck

Specie aliene
Pietro Genovesi

Il design come attitudine
Alice Rawsthorn

Modi di essere
James Bridle

La crisi della narrazione
Byung-Chul Han

L'intelligenza condivisa: Vivere e lavorare insieme all'AI
Ethan Mollick

Il volume del tempo III
Solvej Balle

L'ultima acqua
Chiara Barzini

Technopoly
Neil Postman

Il viaggio di Veronica
Ferdinando Scianna

Civiltà dello sguardo
Francesco Dondina

Cose umane
Antonio Pascale

In viaggio. Il volume del tempo II
Solvej Balle

L'enigma. Il volume del tempo
Solvej Balle

Un'altra idea dell'India
Matteo Miavaldi

Visus
Riccardo Falcinelli
Orbital
Samantha Harvey

Io che non ho conosciuto gli uomini
Jacqueline Harpman

A quattro zampe
Miranda July